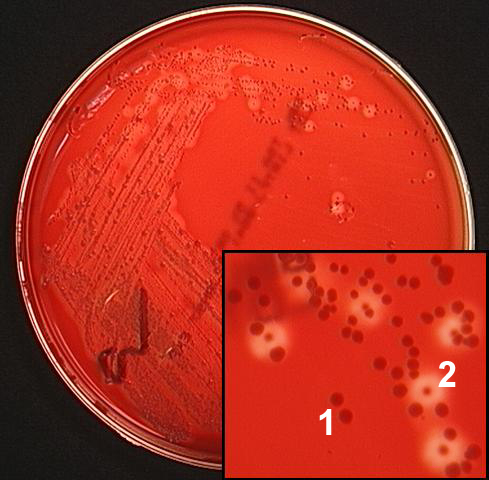

![]()
Created by
Paul A. Gulig, Ph.D.
Department of Molecular Genetics and Microbiology
with assistance from
David Brumbaugh
OK, so you streaked the sample on Blood Agar and MacConkey plates. You incubate the plates overnight at 37 C. Here is an image of the blood agar plate from case 1. Two different colony types - #1 and #2 - are labeled (note that two colonies of #2 are located near the label). We'll deal with the MacConkey plate later. Actually, there is a third colony type marked with a *, but we'll deal with that at the end of this case.
Let's work up colony #1 first, then come back for colony 2.
Let's work up colony #1 first, then come back for colony 2.
How would you describe colony #1?
A. Beta-hemolytic and large.
B. Alpha hemolytic and small.
C. Gamma-hemolytic and large.
D. Beta-hemolytic and small.
What will you do next with colony #1?
A. Test for antibiotic resistance.
B. Perform a Gram stain.
C. Do a PCR.
D. All of the above.